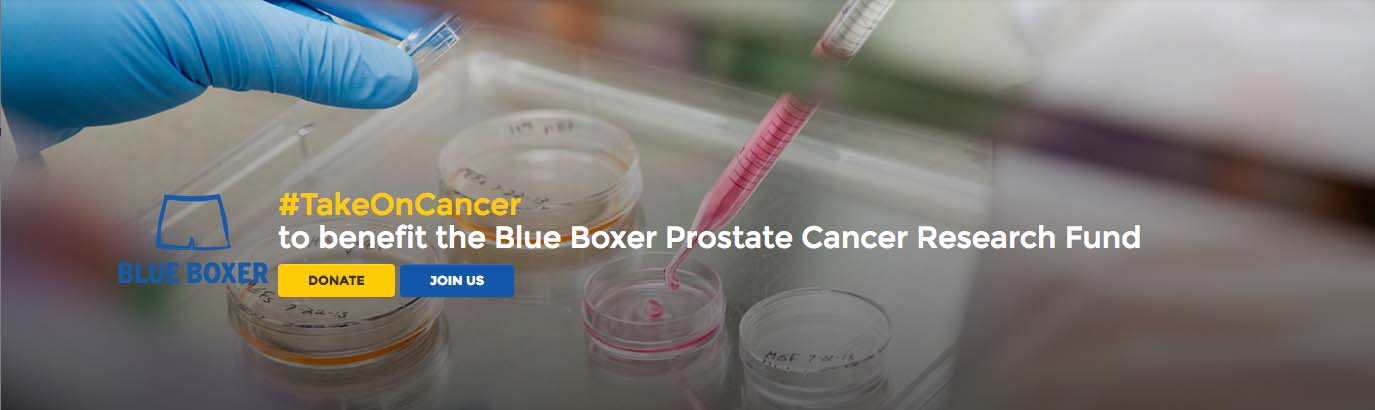

Bare Your Blues for Father’s Day
Help take on prostate cancer
PR Newswire, ANN ARBOR, Mich. (June 15, 2016)
Does your dad or husband need another tie for Father’s Day? Probably not.
This year, give the gift of making a difference and take on prostate cancer by baring your blues and supporting the Blue Boxer Fund for prostate cancer research.
One in seven men will hear the words “it’s prostate cancer” in his lifetime. While research progress has been made, prostate cancer remains the second deadliest cancer among men.
With your support, we can take on prostate cancer and give the men in our lives hope. Hope for new treatments, as well as detection and prevention strategies that pave the way for a long, healthy life.
Inspired to make a difference, a group of patients, including Gary Andrus and John Loussia, established the Blue Boxer Prostate Cancer Research Fund at the University of Michigan Comprehensive Cancer Center. Using blue boxers as a symbol of solidarity in the face of prostate cancer, the goal is to beat the disease through accelerated research and discovery at U-M with one of the world’s top prostate cancer research teams.
I’m baring my blues to take on #prostatecancer! #BlueBoxer Tweet
Using a pioneering approach to cancer called precision medicine, U-M's prostate cancer team is identifying new methods to determine the unique and complex nature of each instance of the disease. This will transform the way prostate cancer is treated around the world.
Scientists use each tumor's genomic profile to identify the specific gene mutations that started the disease, the way the particular genes are clustered, and the stage and rate of the cancer's progression. Researchers are also studying the specific biological events that fuel variations in the cancer’s behavior.
Building on these efforts, U-M's multidisciplinary experts have undertaken an ambitious and comprehensive research initiative to distinguish between different kinds of prostate cancers; to develop targeted therapies that precisely attack them at the molecular level; and to bring the vision of personalized oncology to fruition within the next decade.
Now, we are asking you to join us and Absopure, who has committed to match dollar-for-dollar all donations made to the Blue Boxer Fund from Wednesday, June 15, through Monday, June 20, 2016. Every contribution – no matter the size – matters as we raise awareness and much-needed funds for prostate cancer research.
This Father’s Day, consider donating to support groundbreaking research, share with friends, or launch your own online fundraising page TODAY to benefit the Blue Boxer Fund.
Don’t be modest … bare YOUR blues! Together, we can take on — and uncover cures for — prostate cancer.
Resources:
U-M Cancer AnswerLine, 800-865-1125
Prostate cancer at U-M, www.mcancer.org/prostate-cancer
Clinical trials at U-M, www.mcancer.org/clinicaltrials
Blue Boxer Fund, http://friends.umich.edu/take-on-cancer
# # #
For more information, contact:
Scott Redding, [email protected]
734-764-2220